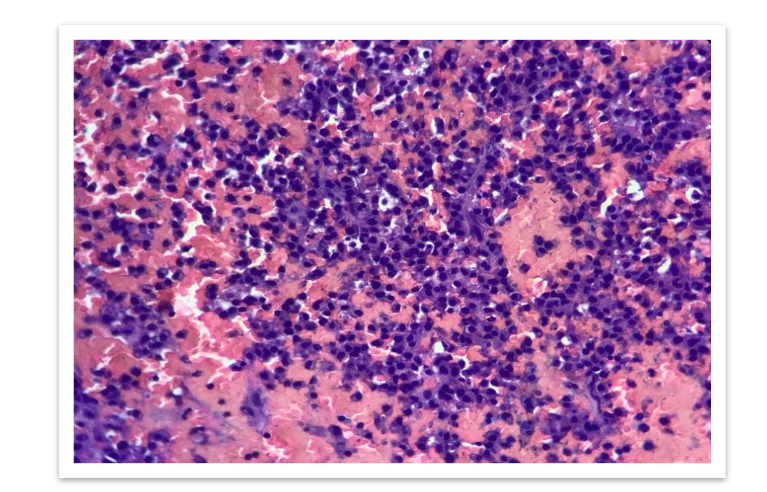
FIG 4: High power view(100x) - Clusters of plasma cells with eccentric nucleus and basophilic cytoplasm.

Uncommon Variant of Non-Secretory Myeloma: A Case Study
The Hidden Enemy: A Case Report on an Uncommon Variant of Non-Secretory Myeloma
Dr. Shobana B¹⁴, Dr. Annie Nitisha. C²⁴, Dr. S. Mary Lilly³⁴
- Associate Professor in Pathology
- Assistant Professor in Pathology
- Professor & HOD in Pathology
- Department of Pathology, Sree Balaji Medical College and Hospital, Chrompet, Chennai-44
OPEN ACCESS
PUBLISHED: 31 May 2025
CITATION: Shobana B., et al., 2025. The Hidden Enemy: A Case Report on an Uncommon Variant of Non-Secretory Myeloma. Medical Research Archives, [online] 13(5).
https://doi.org/10.18103/mra.v1316.6610
COPYRIGHT: © 2025 European Society of Medicine. This is an open-access article distributed under the terms of the Creative Commons Attribution License, which permits unrestricted use, distribution, and reproduction in any medium, provided the original author and source are credited.
DOI https://doi.org/10.18103/mra.v1316.6610
ISSN 2375-1924
ABSTRACT
Multiple myeloma is a malignant proliferation of plasma cells producing a monoclonal paraprotein. Multiple myeloma can present in a wide range of ways for example hypercalcaemia, hyper viscosity, renal failure and bone pains/fractures. We report a case of non-secretory multiple myeloma presented with only symmetrical recurrent joint swelling. This patient had no other symptoms and his serum basic biochemical analyses were normal. He had normal serum protein in electrophoresis and negative for urine Bence Jones protein. Histologically, loosely arranged clusters of plasmacytoid cells are seen which were CD138 positive, confirming the diagnosis of non-secretory plasma cell myeloma. To diagnose cases of multiple myeloma with normal serum electrophoresis, a high index of suspicion is needed.
Keywords: Plasma cell myeloma, Multiple myeloma, Non secretory type.
Introduction
Multiple myeloma (MM) is a malignant proliferation of plasma cells producing a monoclonal paraprotein causing Gammopathy, as well as CRAB characteristics (bone lesions, anemia, hypercalcaemia, and renal insufficiency).¹
The disease has a wide range of symptoms from asymptomatic to quite aggressive². It accounts for about 1% of malignant tumours, 10–15% of haematopoietic neoplasms, and 20% of deaths from haematological malignancies.³⁴ Physical findings are often absent or nonspecific, with pallor being the most common.
In about 97% of cases, M protein is found in the serum or urine. Light chains alone or in combination with heavy chains, which are also present in urine, are indicative of the proliferation of this monoclonal (M) protein.⁴
MM can be classified as light chain (kappa and lambda), double clone, non-secretory, IgG, IgA, IgD, IgM, and IgE types based on the type of M protein.⁵
Non-secretory myeloma (NSMM), a rare myeloma subtype, lacks the secretion of immunoglobulins.⁶ Two to four percent of all patients with multiple myeloma have non-secretory myeloma, which has evolving diagnostic criteria. This unusual variant is characterised by 10% of monoclonal plasma cells in the bone marrow, end-organ damage, or a biopsy that demonstrates the presence of a plasmacytoma and negative results on serum, urine electrophoresis, and immunofixation tests.⁵⁶
Bone marrow study and histopathological examination plays a key role in the diagnosis. Due to its rarity, this variant typically presents a diagnostic problem to medical professionals.¹⁵
In order to improve knowledge of NSMM, this case report will cover the pathophysiologic process of its non-secretion character and discuss its implications for clinical diagnosis, treatment, and prognosis.
Case Report
A 70 years old male was admitted to the hospital with the complaints of pain in the left hip and difficulty in walking for the past 1 week. On examination, no swelling present, pain was dull aching type, continuous, aggravated on walking, standing and relieved on rest & medication. Left hip tenderness present in the anterior joint line, bi-trochanteric compression- positive and restriction of movements were noted.
MRI Hip (left) revealed undisplaced fracture in the femoral neck, multiple focal altered signal intensity lesions in the proximal femur and pelvic bone. HRCT chest showed expansile lytic lesions with bone erosions in the posterolateral aspect of left 6th rib; Multiple target lytic lesions in cervical and thoracic vertebrae. Impression was given as metastasis can be considered.
All of the blood values were unremarkable. Total WBC count was 5360/cu.mm, ESR was 75mm, Hb was 11.2gm/dl, RBC was 3.39 million, and Platelets were 1.85 lakh. Thyroid function tests, serum amylase, lipase, clotting time, and bleeding time were all normal. Urine routine showed protein 2+. Serum calcium was 10 mg/dl, serum phosphorus was 3.7 mg/dl, and serum alkaline phosphatase was 87 IU/L. Following all of the tests, the clinical diagnosis was reported as a pathological fracture of the left neck of the femur with several lytic lesions in the B/L proximal femur, pelvic bone, thoracic lumbar vertebras and 6th rib without shortening. A Dynamic Hip Screw procedure was performed on the left hip, and the tissue sample was sent for histological evaluation.
On gross examination, we received multiple grey brown to grey black soft tissue fragments altogether measuring 0.5cc, all the tissue was embedded in paraffin. Before grossing, tissue samples were fixed in 10% buffered neutral formalin. Sections were processed and stained with hematoxylin and eosin.
Microscopically, loosely arranged clusters of plasmacytoid cells, some are seen embedded in an eosinophilic osteoid like stroma. Few areas showed neutrophilic infiltration, spicules of degenerated bone, areas of haemorrhage and few bundles of striated muscle fibres. It was reported as Plasma cell malignancy- probably multiple myeloma (Non secretory type) as serum protein electrophoresis was normal.


Bone marrow biopsy was performed, which showed a hypercellular marrow with increased plasma cells constituting more than 20% of total leukocytes. The plasma cells were positive for CD138, confirming the diagnosis of non-secretory multiple myeloma.

FIG 6: Immunohistochemistry shows plasmacytoid cells are positive for CD 138.
Discussion
Plasma cell myeloma (PCM) is a bone marrow-based, multifocal neoplastic proliferation of plasma cells, usually accompanied by the production of a monoclonal immunoglobulin detectable in the serum, urine or both.³⁴⁷ Multiple myeloma (MM); medullary plasmacytoma; myelomatosis; Kahler disease (no longer used) are the synonyms used.⁴ It accounts for about 1% of malignant tumours, 10–15% of haematopoietic neoplasms, and 20% of deaths from haematological malignancies.³⁴ The peak incidence is in seventh decade; the disease is slightly more frequent in males than females.³ Osteolytic lesions in the skull, ribs, sternum, vertebrae and pelvis are present in approximately 70% of cases; in rare cases x-ray films reveal osteosclerotic lesions²³. It is a slowly proliferating tumor, typically with less than 1% of tumor cells synthesizing DNA, until late in the disease, when multiple myeloma cells are often found outside the bone marrow. A pre-malignant lesion called monoclonal gammopathy of undetermined significance (MGUS), which is present in 1% of adults, progresses to malignant multiple myeloma and plasma cell Leukemia at a rate of 1% per year.⁷⁸¹¹ There are several clinical variants, including asymptomatic or smoldering myeloma, non-secretory myeloma and plasma cell Leukemia.¹¹
Non-secretory multiple myeloma (NSMM) is a rare variant of multiple MM that has a similar clinical and radiologic presentation except for the absence of the M-protein in serum and/or urine.⁹¹² According to previous researches, NSMM may not have detectable monoclonal free light chain in urine/serum, as seen in our case after thorough investigatory work up.¹³ Approximately 1% of Plasma Cell Myelomas are nonsecretory.²⁴⁷ Cytoplasmic M protein is present in the neoplastic plasma cells in about 85% of cases when evaluated by immunohistochemistry, consistent with production but impaired secretion of Immunoglobulin (Ig)²⁴. Acquired mutations of the Ig light chain variable genes and alteration in the light chain constant region have been implicated in the pathogenesis of the non-secretory state.⁴⁹¹³ The clinical features of non-secretory myeloma are similar to those of other PCMs, except for a lower incidence of renal insufficiency and hypercalcaemia and less depression of normal Ig and prognosis of non-secretory myeloma are similar to those of other PCMs.⁴⁹ Survival appears to be better for patients with a normal baseline serum free light chain ratio than those with an abnormal ratio.⁴¹⁰ Non-secretory myeloma must be distinguished from the rare IgD and IgE myelomas, which have low serum M protein and may not be routinely screened by immunofixation electrophoresis.⁴⁹ Smoldering (asymptomatic) plasma cell myeloma patients have 10–60% clonal plasma cells in their bone marrow and/or an M protein at myeloma levels but absence of myeloma-defining events and amyloidosis.³⁴ In Plasma cell leukemia variant, clonal plasma cells constitute > 20% of total leukocytes in the blood or the absolute count is >2.0 x 10⁹/L.⁴
Conclusion
The absence of a monoclonal protein in serum and/or urine does not rule out the diagnosis of Multiple Myeloma. Indeed, the diagnosis of non-secretory myeloma should be made in patients with clinico-pathological and radiological characteristics of Multiple Myeloma with a ratio of normal Kappa/Lambda free light chains. This case demonstrates that non-secretory myeloma should be considered in individuals with a negative M protein, and that diagnosing cases of multiple myeloma with normal serum electrophoresis requires a high degree of suspicion.
References
1. Kelley MA, Mestre A, Ayau MF, Arora A, Khillan R, et al. A Case Report of Non-secretory Multiple Myeloma. Cureus. 2022;14(9):e29571. doi:10.7759/cureus.29571.
2. Kumar V, Abbas AK, Fausto N. Robbins and Cotran pathologic basis of disease. W B Saunders Co. (2017) ISBN:0721601871.
3. John R. Goldblum, Jesse K. McKenney, Rosai and ackerman’s surgical pathology, eleventh edition.
4. WHO Classification of tumors of haematopoietic and lymphoid tissues (fifth edition).
5. Geng Qianshuang, Jie Li, Xi Li, Zhang Wenjie, Zhang Guoxiang, Ge Li, Liang Li, et al. A case report: Nonsecretory multiple myeloma presenting with bone pain. Medicine. Feb 02, 2024;103(5): e36951. DOI: 10.1097/MD.0000000000036951.
6. Dimopoulos MA, Kastritis E, Terpos E, et al. Non-secretory myeloma: one, two, or more entities? Oncology (Williston Park). 2013;27:930-2.
7. Ana Rita Caldas, Mariana Brandao, Antonio Marinho, et al. Non-Secretory Myeloma or Light Chain-Producing Multiple Myeloma: A Case Report. Journal of Medical cases. 2011;2(3):97-100.
8. Kuehl WM, Bergsagel PL, et al. Multiple myeloma: evolving genetic events and host interactions. Nat Rev Cancer. 2002;2(3):175-187.
9. Mohammed Bensalah, Somiya Lamrabat, et al. A rare case of non-secretory multiple myeloma: a case report and literature review. The Journal of the International Federation of Clinical Chemistry and Laboratory Medicine. 2019 Mar;30(1): 88–94.
10. Jordana Cheta, Michael Binder, et al. A Case Report of Multiple Myeloma Associated with Myeloperoxidase and Proteinase-3 Antibodies Posing a Diagnostic Dilemma. Journal of Investigative Medicine High Impact Case Reports. 2019;7: 1–5
11. Neeraja Swaminathan, Sorab Gupta, Claudia Dourado, et al. Case Report: IgG multiple myeloma and chronic myeloid leukemia in a single patient myeloma and chronic myeloid leukemia. F1000Research, 2020;9:488.
12. Dimopoulos M, Kyle R, Fermand JP, et al. Consensus recommendations for standard investigative workup: report of the International Myeloma Workshop Consensus Panel 3. Blood. 2011;117:4701-5.
13. Dupuis MM, Tuchman SA: Non-secretory multiple myeloma: from biology to clinical management. Onco Targets Ther. 2016, 9:7583-90. 10.2147/OTT.S122241.




